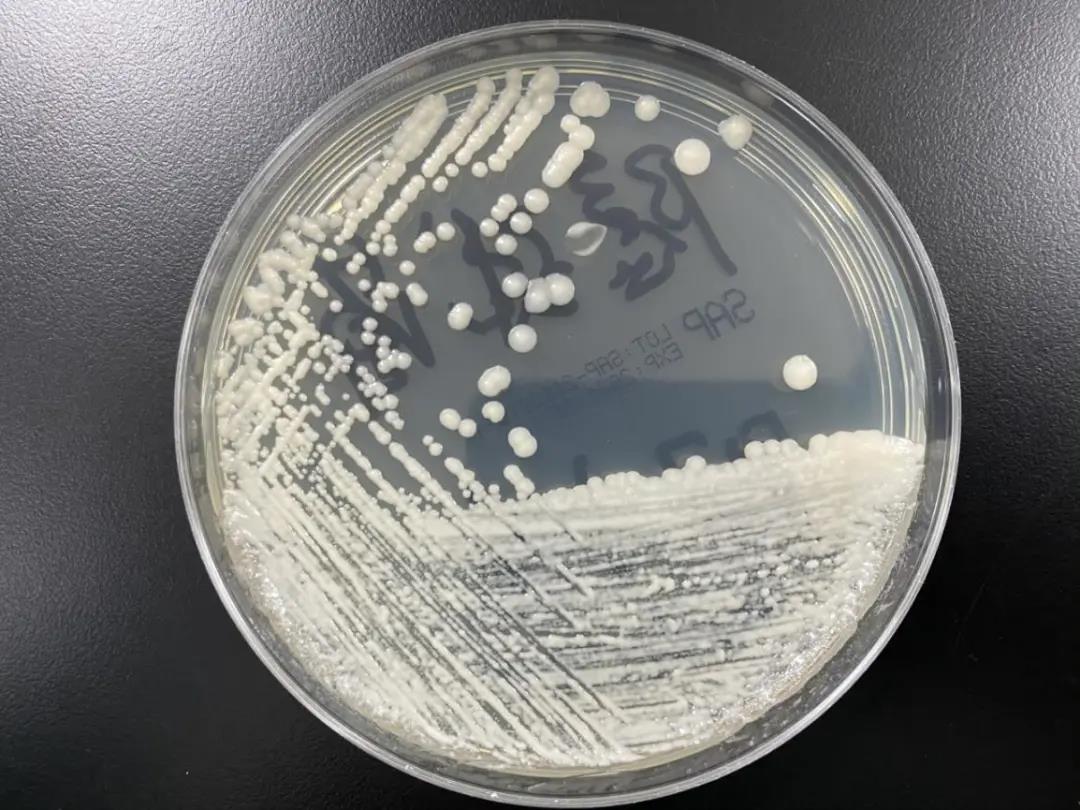

查看更多
密码过期或已经不安全,请修改密码
修改密码
壹生身份认证协议书
同意
拒绝
同意
拒绝
同意
不同意并跳过
案例经过
患者,男,66岁,农民,因“间断头痛1月,加重2天”于2021年3月9日入院。
该患者1月前无明显诱因出现头痛,伴有恶心未吐,无发热流涕,无视物模糊,无四肢肢体抽搐无力,无咳嗽、咳痰,无腹痛、腹泻等不适,于当地医院住院予“抗病毒、止痛”等对症治疗,患者头痛有所好转。
入院前一天患者头痛再次发作,为求进一步诊治,门诊以“头痛待查”收住我院。有高血压病史,否认糖尿病、结核、癫痫病史,否认手术外伤史,否认药敏史。
入院查体显示:T 36.4℃,P 72次/分,R 19次/分,BP 177/98mmHg,神志清楚,双侧瞳孔等大等圆,对光反射灵敏,四肢肌力肌张力正常,腱反射对称存在,双侧针刺觉对称,双下肢病理反射征未引出。
颈项强直4横指,克氏征阳性。脑影像学检查:脑MR平扫+增强提示双侧小脑半球多发软脑膜异常强化灶,初步诊断脑膜炎。
入院当天实验室检查结果示:中性粒细胞数:6.36×109 /L↑,中性粒细胞百分率:90.6%↑,淋巴细胞数:0.4×109/L↓,降钙素原:0.1 ng/mL,CA72-4:9.78 U/mL↑,FERRITI:435.85 ng/mL↑,凝血功能及常规输血全套结果均无异常。
入院第二天因患者病情需要,在征得患者及家属同意后,管床医生为患者行腰穿,获取无色澄清透明脑压为330毫米水柱↑的脑脊液。
案例分析
初步分析:该患者存在头疼症状且脑膜刺激征呈阳性反应,结合其影像学表现,临床初步诊断为脑膜炎。那么,该患者是感染性还是非感染性脑膜炎呢?
非感染性脑膜炎常见病因:
1.脑血管意外:该病亦可出现四肢抽搐、意识丧失等症状,但该病多既往有心脑血管及糖尿病等基础疾病,且该患者无外伤史,暂不考虑;
2.蛛网膜下腔出血:可出现剧烈头痛,但该患者脑脊液无色澄清透明,而蛛网膜下腔出血后脑脊液黄色或红色加以鉴别,且门诊资料显示该患者头MR未见出血,综上所述该患者感染性脑膜炎可能性较大;而感染性脑膜炎常由细菌、病毒、真菌和寄生虫等所致。我们进一步分析该患者脑脊液相关检查如下图所示。

图1 脑脊液常规检查

图2 脑脊液细胞学检查

图3 脑脊液生化检查
根据《临床检验基础》教材中对常见脑膜疾病的脑脊液检验鉴别见表1,结合该患者脑脊液检验结果(图1至图3)我们综合分析:
首先该患者脑脊液理学检查结果为无色透明且无凝块,初步排除化脓性脑膜炎、结核性脑膜炎、脑出血、蛛网膜下腔出血等脑膜疾病;
其次患者脑脊液氯化物下降,脑脊液蛋白增多,脑脊液葡萄糖正常且结合细胞学检查发现细胞总数增多以淋巴细胞明显增加为主,中性粒细胞仅占约3%,进一步排除病毒性脑膜炎、流行性乙脑、脑肿瘤脑脓肿、神经性梅毒。
此时,我们高度怀疑该患者存在隐球菌性脑膜炎的可能性较大。随即联系该患者的主治医师开隐球菌相关检测项目。
隐球菌性脑膜炎是由隐球菌感染脑膜或脑实质引起的中枢神经系统感染性疾病,是中枢神经系统最常见的机会性真菌感染,好发于细胞免疫功能低下者,如AIDS、恶性肿瘤、糖尿病、器官移植及大剂量使用糖皮质激素者。
近年来,由于广谱抗菌药物、糖皮质激素、化疗药物、免疫抑制药物的广泛应用及免疫缺陷性疾病和器官移植的增加,隐球菌性脑膜炎发生率大幅上升,显著高于病毒性脑膜炎和结核性脑膜炎。
隐球菌是酵母类真菌,广泛存在于自然界中,也可存在于人体皮肤、口腔及肠道中。引起人类感染的隐球菌主要是新型隐球菌和格特隐球菌,新型隐球菌和格特隐球菌常统称为新型/格特隐球菌复合(Cryptococcus gattii/neoformans species complexes)。
根据传统分型,新型隐球菌包括3个变种,即新型隐球菌格鲁比变种(血清型A型,Cryptococcus neoformans variety Grubii)、新型隐球菌新生变种(血清型D型,Cryptococcus neoformans variety neoformans ) 和新型隐球菌混合变种(血清型AD型,Cryptococcus neoformans AD hybrid)。
由于隐球菌性脑膜炎临床表现及影像学检查多无特异性,其诊断主要依赖于实验室检查。常用的实验室诊断方法包括脑脊液显微镜下直接检测、真菌培养、荚膜抗原检测及分子生物学检测。
表1

微生物学组收到脑脊液标本。外观:无色透明。首先将脑脊液标本离心处理后收集沉淀,并进行墨汁染色后进行镜下检测。印度墨汁涂片直接镜检:可见圆形或卵圆形的有折光性菌体,其周围有一圈透亮的厚荚膜,内有反光孢子,基本确定为隐球菌。见图4。与此同时,用该患者血清加做荚膜抗原检测,结果显示该患者血清荚膜抗原为阳性。见图5。

图4墨汁染色

图5 荚膜抗原检测
随后我们为了进一步鉴定,我们将脑脊液标本接种在沙氏培养基上,利用病原性隐球菌在25℃和37℃孵育均可生长,而非病原性隐球菌在37℃时不生长特性。我们将接种好的培养基放入37℃培养箱里,48h后观察菌落是否生长。
经过37℃48h培养,沙氏平板上可见生长茂密、呈奶油色、蜡样光滑,黏稠的酵母样菌落,见图6。
图6 分离培养
为了大大缩短鉴定时间及能很好地区分隐球菌不同血清型和分子型,我们用基质辅助激光解析电离飞行时间质谱(MALDI-TOFMS)进行鉴定。最终结果为新型隐球菌格鲁比变种(血清型A型,Cryptococcusneoformans varietyGrubii),分值1.986分。结果及峰图分别见图7和图8。


图7

图8
参照酵母菌肉汤稀释法药敏试验标准,用微量肉汤稀释法ATBFungus 真菌药敏试条进行药敏实验结果如下:5-氟胞嘧啶(5-FC)、氟康唑(FCA)、两性霉素B(AMB) 均敏感。
总 结
新型隐球菌广泛分布于自然界,以出芽的方式生殖,免疫低下的人群更易被感染。治疗时间长,致死率、致残率较高,因此早期、精准诊断显得尤为重要。
早期主要依靠临床医师的高度警惕,怀疑出现脑病时应及时行脑脊液检查,目前实验室可以应用传统病原学检测手段包括墨汁染色、真菌培养、荚膜抗原检测以及分子生物学方法包括PCR、质谱分析法、宏基因组下一代测序等技术,联合应用可提高隐球菌的检出率。
作为检验工作者的我们除应具备专业技能,还应该多多主动与临床沟通,以及时找到病因使患者得到有效的治疗。
作者:荆州市中心医院医学检验部 夏巍
文章首发自检验医学
查看更多